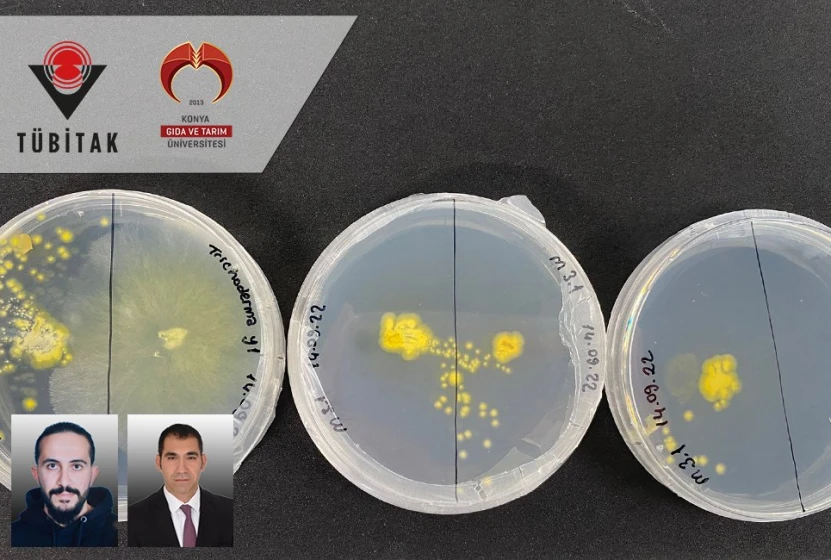

Öğrencilerimiz "Farm Robotics Challenge" Yarışmasında!
2026-01-28 07:25:29
Üniversitemizde SHT-İHA Talimatına Uygun “İHA-1 Ticari Pilot Eğitimi” Başarıyla Tamamlandı
2026-01-26 06:53:16
Erciyes Eğitim Kurumu, Üniversitemizde Kamp Programı Kapsamında Misafir Edildi
2026-01-23 14:03:13